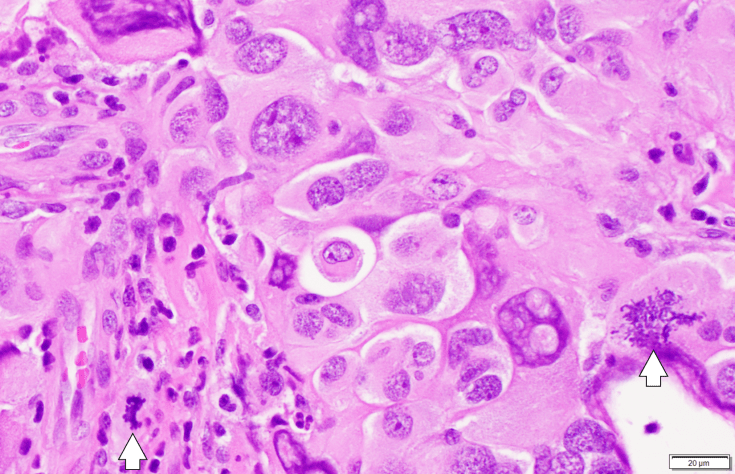
giant cell GBM and granular mitoses

Giant Cell Glioblastoma, also called magnocellular or monstrocellular glioblastoma, is characterized by atypical cells that are extremely large, especially when compared to the non-neoplastic inflammatory cells seen on the left side of the image. The tumor has increased number of dividing cells, including typical mitotic figures (bottom left arrow) and atypical or granular mitoses (bottom right arrow).

Leave a comment